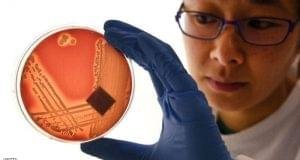

قال البروفيسور الألماني إنجو فروبوزه إن الدش البارد غير مناسب ...
أكمل القراءة »الرئيسية / الصحة (صفحة 109)
تجربة مخبرية تكشفُ ما يفعله فيروس «كورونا» بالقلب
كشفت دراسة طبية حديثة، أن فيروس كورونا المستجد قد يكون ...
أكمل القراءة »تجربة على الخنازير تثبت فاعلية لقاح ضد كورونا
أثبتت تجربة على الخنازير فاعلية أكبر للقاح أسترازينيكا المضاد لكوفيد-19 ...
أكمل القراءة » صحيفة خلف الكواليس موقع خلف الكواليس متخصص بالاخباري المحليه أول بأول
صحيفة خلف الكواليس موقع خلف الكواليس متخصص بالاخباري المحليه أول بأول